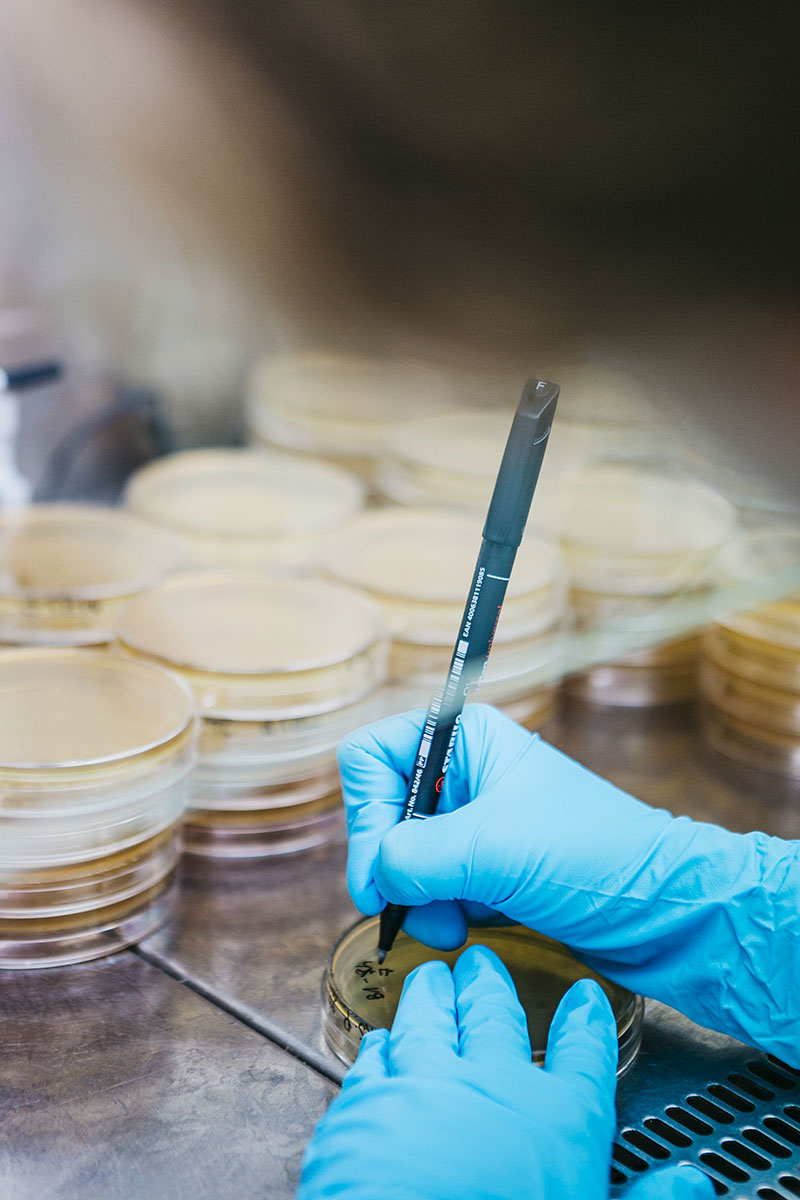

Estudios y otros servicios
Las situaciones de alerta y crisis alimentaria requieren de una rápida y coordinada respuesta por parte de las empresas e instituciones en ellas implicadas de forma directa e indirecta. En estas situaciones, resulta de gran importancia contar con el máximo nivel de información alcanzable en el menor espacio de tiempo posible.
Para poder tener ese nivel de información máximo, de forma rápida y fiable, las empresas alimentarias requieren de un soporte técnico ágil, capaz de dar rápida respuesta con las máximas garantías científico-técnicas.
Un equipo profesional evalúa la situación y facilita información técnica rigurosa sobre la alerta, de manera que tu empresa pueda tomar las mejores decisiones sobre inmovilización de producto, la comunicación de la incidencia a los afectados y la adopción de medidas correctoras necesarias.
| Responsable | AINIA |
| Domicilio | Calle Benjamín Franklin, 5 a 11, CP 46980 Paterna (Valencia) |
| Finalidad | Atender, registrar y contactarle para resolver la solicitud que nos realice mediante este formulario de contacto |
| Legitimación | Sus datos serán tratados solo con su consentimiento, al marcar la casilla mostrada en este formulario |
| Destinatarios | Sus datos no serán cedidos a terceros |
| Derechos | Tiene derecho a solicitarnos acceder a sus datos, corregirlos o eliminarlos, también puede solicitarnos limitar su tratamiento, oponerse a ello y a la portabilidad de sus datos, dirigiéndose a nuestra dirección postal o a privacy@ainia.es |
| Más info | Dispone de más información en nuestra Política de Privacidad |
| DPD | Si tiene dudas sobre como trataremos sus datos o quiere trasladar alguna sugerencia o queja, contacte al Delegado de protección de datos en info@businessadapter.es o en el Formulario de atención al interesado |
Consiento el uso de mis datos personales para que atiendan mi solicitud, según lo establecido en su Política de Privacidad.
Consiento el uso de mis datos para recibir información y comunicaciones comerciales de su entidad.
